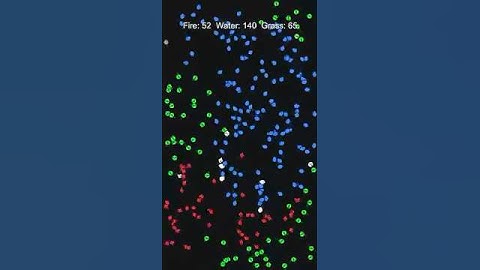
Fire vs Water vs Grass: Rock–Paper–Scissors Chaos #unity #rockpaperscissors #citypop

⬇ DOWNLOAD NOW
Jika muncul iklan pop-up, tutup lalu klik tombol kembali
Download lagu Fire vs Water vs Grass: Control Is an Illusion—Until It Breaks #rockpaperscissors #unity #simulation secara gratis hanya untuk keperluan promosi. Dukung artis favorit kamu dengan membeli musik original di iTunes atau platform resmi lainnya.
 Fire vs Water vs Grass: Three-Way Standoff #rockpaperscissors #unity #simulation
Fire vs Water vs Grass: Three-Way Standoff #rockpaperscissors #unity #simulation Fire vs Water vs Grass: Rock–Paper–Scissors Chaos #unity #rockpaperscissors #citypop
Fire vs Water vs Grass: Rock–Paper–Scissors Chaos #unity #rockpaperscissors #citypop Fire vs Water vs Grass: Choose, Commit, Become—Make Your Fate #rockpaperscissors #unity
Fire vs Water vs Grass: Choose, Commit, Become—Make Your Fate #rockpaperscissors #unity Fire vs Water vs Grass: Sweet–Savory Dominance—Ganjang Chicken Wins #rockpaperscissors #unity
Fire vs Water vs Grass: Sweet–Savory Dominance—Ganjang Chicken Wins #rockpaperscissors #unity Fire vs Water vs Grass: Few Clicks, Big Money—Or So It Seems #rockpaperscissors #simulation
Fire vs Water vs Grass: Few Clicks, Big Money—Or So It Seems #rockpaperscissors #simulation Fire vs Water vs Grass: Tap, Ship, Scale—Clicks That Compound #rockpaperscissors #rock #unity
Fire vs Water vs Grass: Tap, Ship, Scale—Clicks That Compound #rockpaperscissors #rock #unity Fire vs Water vs Grass: Ode to Strawberries—Ruby Sweet, Fresh Bite #rockpaperscissors #simulation
Fire vs Water vs Grass: Ode to Strawberries—Ruby Sweet, Fresh Bite #rockpaperscissors #simulation Fire vs Water vs Grass: Breath Fog, Numb Fingers, Deadlines Alive #rockpaperscissors #unity
Fire vs Water vs Grass: Breath Fog, Numb Fingers, Deadlines Alive #rockpaperscissors #unity